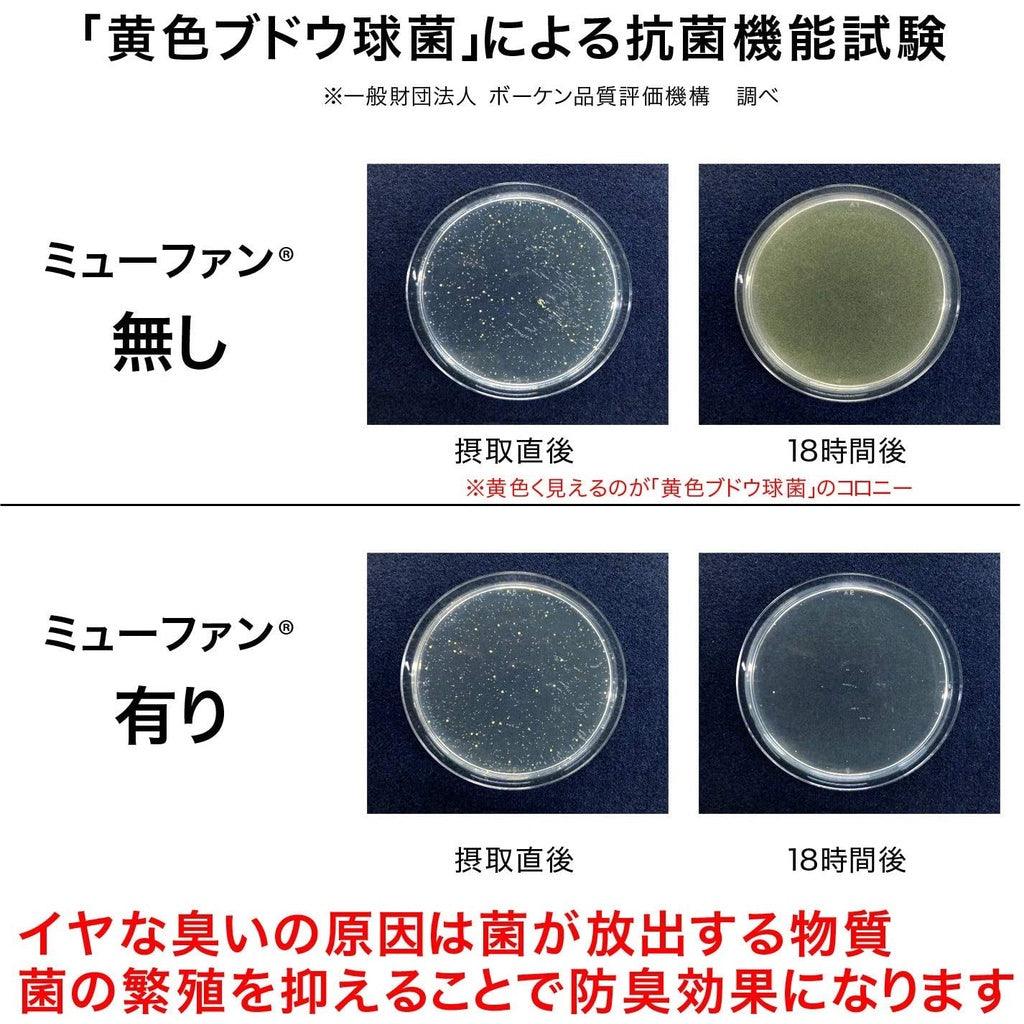
日本製銀離子抗菌除臭超吸水抹布|服部先生推薦 - 富士通販

產品敘述
產品敘述
「即使經過200次洗滌,殺菌效果仍持續不變。」
吸水力非常強!
來自以生產毛巾而聞名的泉州!
這一條特別添加銀離子喔!
強化抗菌效果,吸水力又非常好,
改善一般抹布的易滋生細菌和霉味異味,
擦過馬上沒有水痕喔!
尺寸:約30×40cm
材質:綿100%
產地:日本
吸水力非常強!
來自以生產毛巾而聞名的泉州!
這一條特別添加銀離子喔!
強化抗菌效果,吸水力又非常好,
改善一般抹布的易滋生細菌和霉味異味,
擦過馬上沒有水痕喔!
尺寸:約30×40cm
材質:綿100%
產地:日本
付款方式
支援信用卡和LINE PAY 付款
海外客人支援PAYPAL結帳